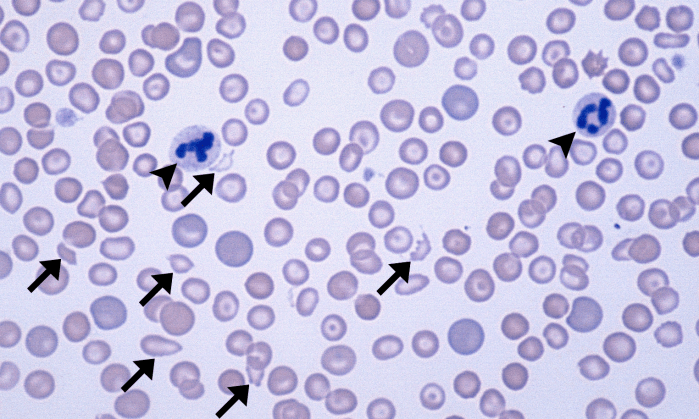
Schizocytes 1 (Canine 1 - DIC) ARROWS

Schizocytes

Also called: schistocytes
Morphology: red blood cell fragments. Usually oblong with irregular margins, but may appear in a variety of shapes and sizes.
Commonly seen with: keratocytes and acanthocytes (if caused by fragmentation injury), microcytosis and hypochromia (if caused by iron deficiency)
Clinical relevance: indicates fragmentation injury to red blood cells related to vascular abnormalities (ie. disseminated intravascular coagulation, glomerular disease, vasculitis, portosystemic shunts, hemangiosarcoma) or mechanical fragility of red blood cells (ie. iron deficiency). Small numbers of schizocytes may be normal in healthy dogs.